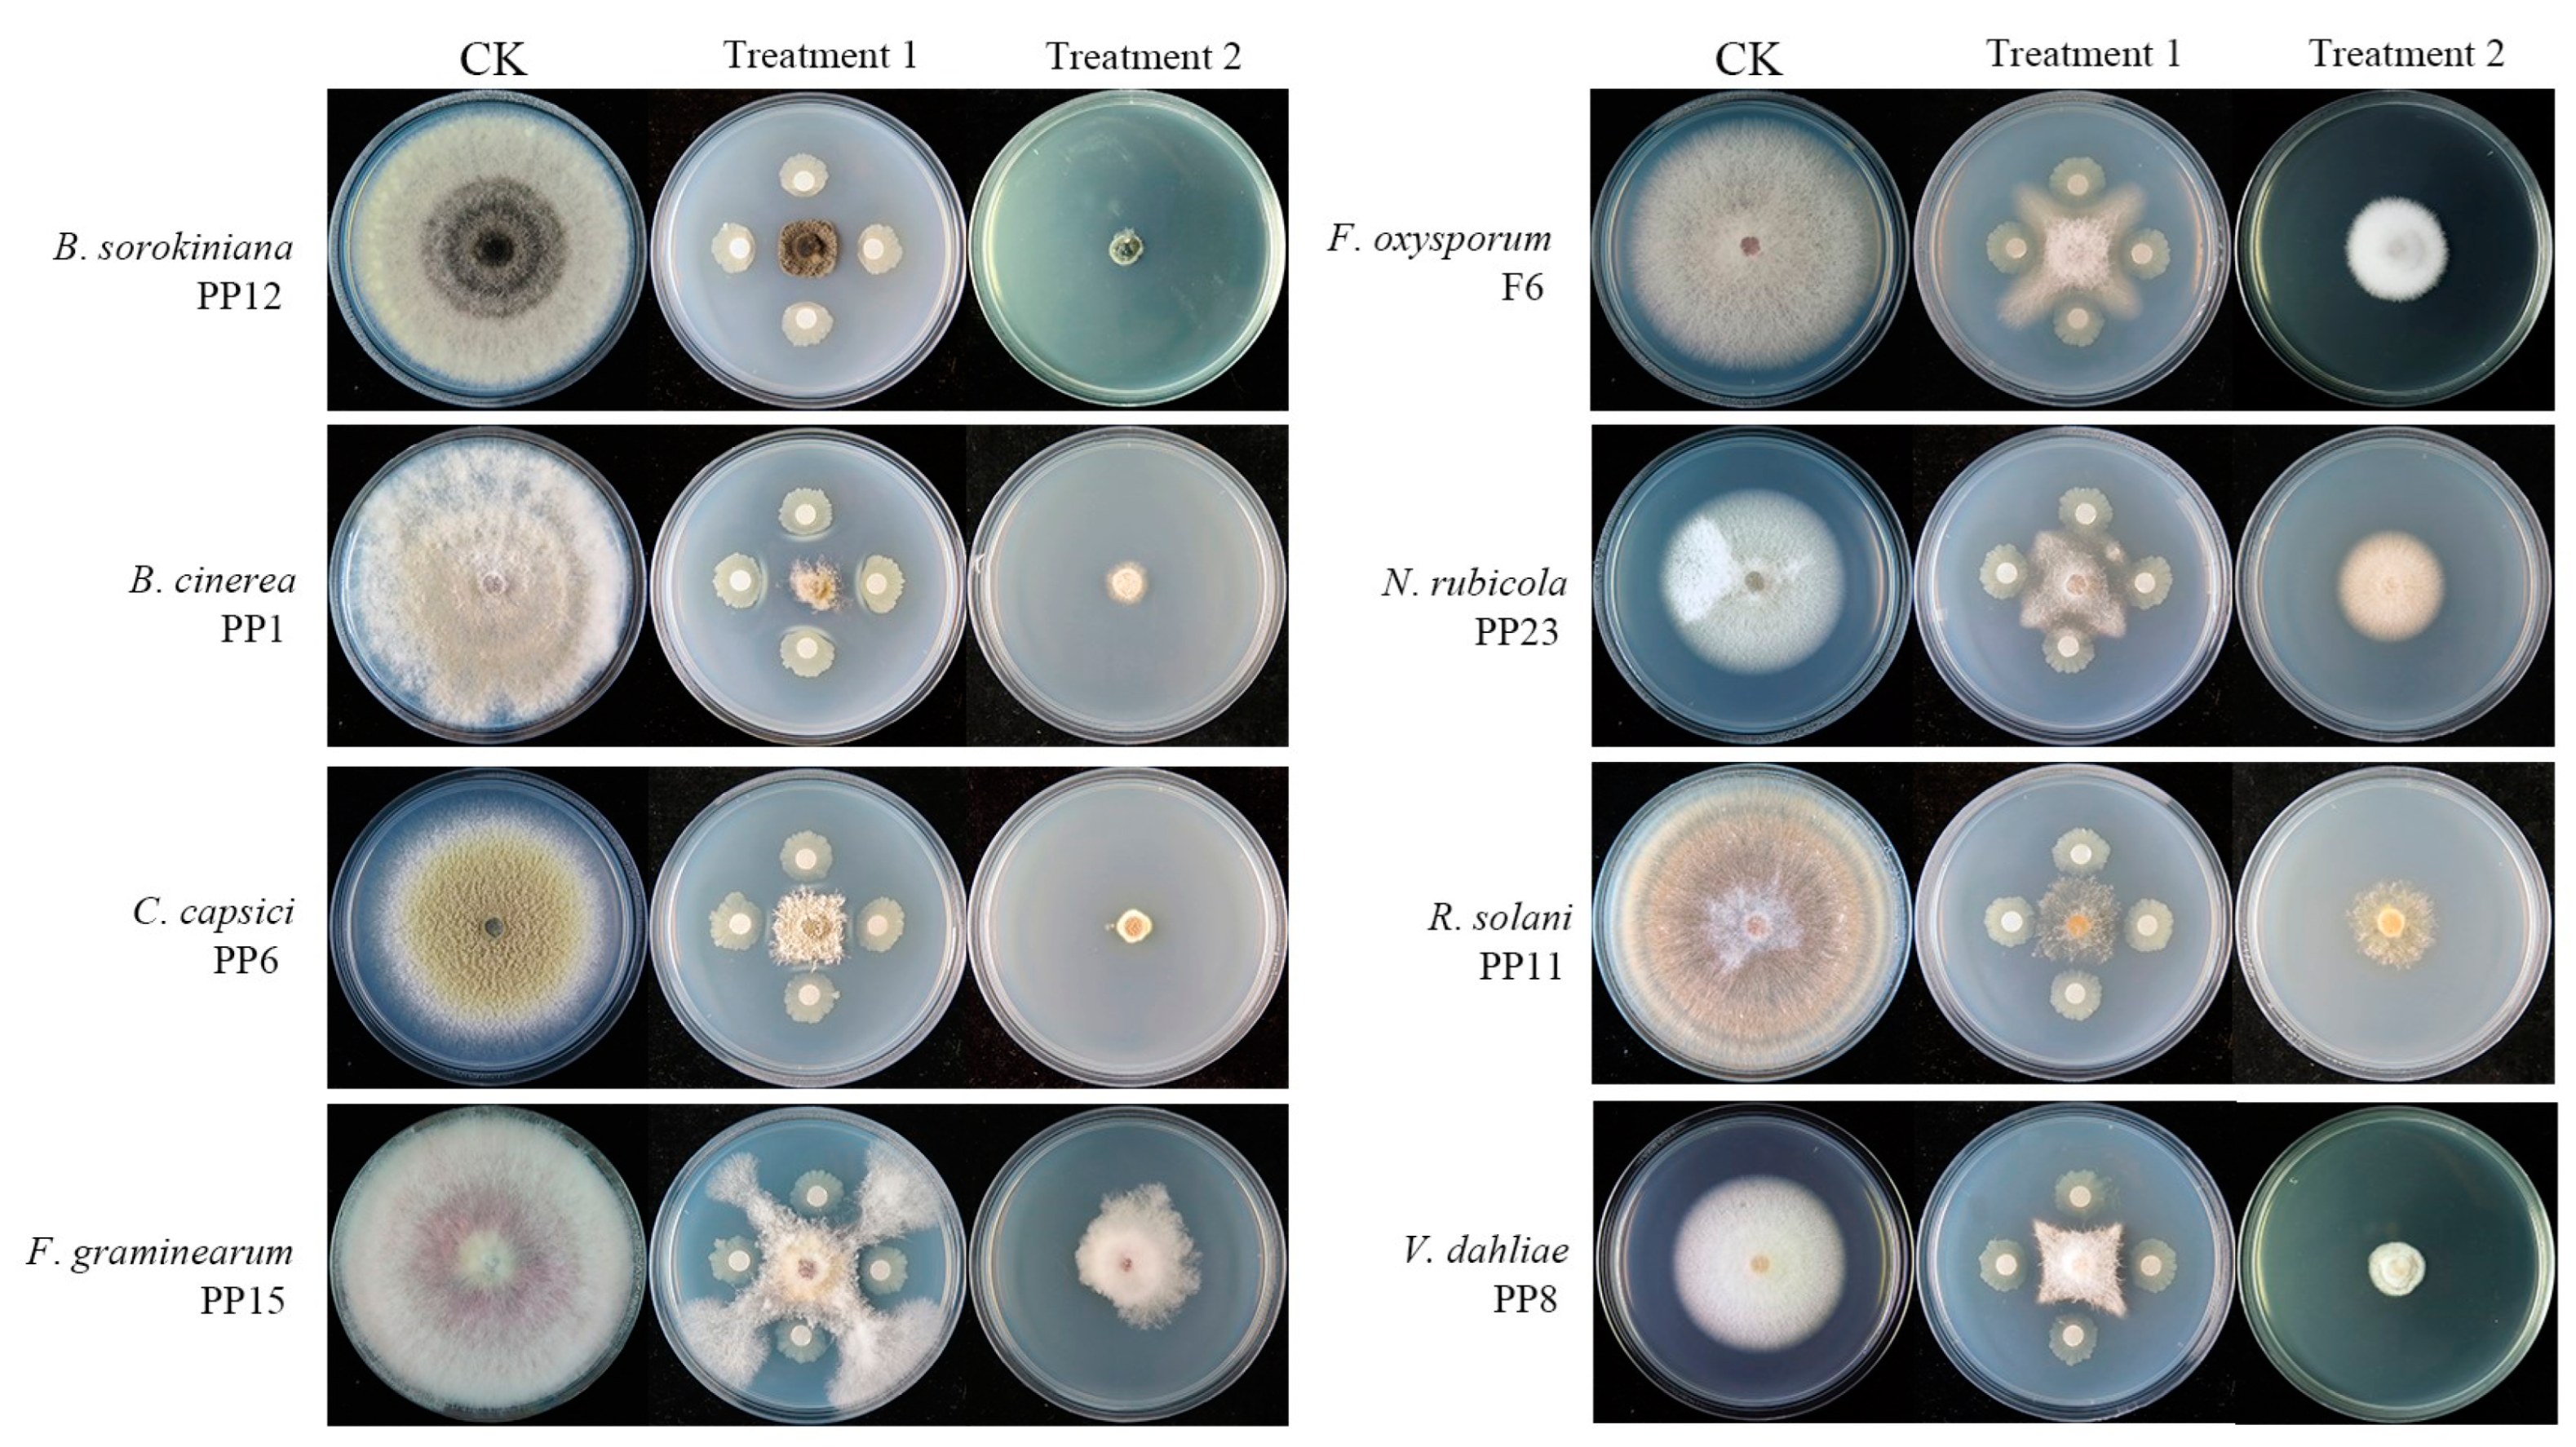
Bacillus velezensis BV01 Has Broad-Spectrum Biocontrol Potential

マイストア
変更
お店で受け取る
(送料無料)
配送する
納期目安:
2025.12.05 13:1頃のお届け予定です。
決済方法が、クレジット、代金引換の場合に限ります。その他の決済方法の場合はこちらをご確認ください。
※土・日・祝日の注文の場合や在庫状況によって、商品のお届けにお時間をいただく場合がございます。
邦楽 the Bacillus Braine C.O.S.M.E THE BACILLUS BRAINS - COSME - YouTubeの詳細情報
THE BACILLUS BRAINS - COSME - YouTube。A native conjugative plasmid confers potential selective。Bacillus velezensis BV01 Has Broad-Spectrum Biocontrol Potential。■アーティスト : ザ バチラス ブレインズ■タイトル : C•O•S•M•ETHE BACILLUS BRAINS(ザ・バチラス・ブレインズ)のメジャーデビューアルバム「C・O・S・M・E」2008年6月4日にリリースされ、ジャケットイラストは空山基氏。Bacillus velezensis stimulates resident rhizosphere Pseudomonas。 アーティスト写真は荒木経惟氏が撮影を担当。frank ocean channel orange 2LP レコード。THE BACILLUS BRAINSは、日本のハードコアバンド「THE日本脳炎」が改名したバンド。GLIM SPANKY/アナログレコード3組セット/愚か者たち・BIZARRE。なお、THE BACILLUS BRAINSは2010年に解散し、その後はjajoukaというバンドで活動。貴重 YMO WORLD TOUR 1980 レコード 3枚組。アナログ盤 限定1000枚【状態】・盤 : 未使用・ジャケット : 目立つ傷や汚れはなく状態は良いと思います。cocona アメリカ us 限定 レコード XG LP AWE vinyl。購入後、長期自宅保管しておりました。ハナタラシ+恐悪狂人団 カセット 極美品。★他に出品中のレコード一覧はこちら。新品未再生 八十八ヶ所巡礼『幻魔大祭』 レコード アナログ 特典カード付き。↓↓↓#オサムのレコード部屋●下記の内容をご理解いただいたうえで、ご購入いただきますようお願いします。G.Rina Plastic Love 7インチレコード。※レコードの特性上、経年劣化で多少の歪み、ノイズ、音飛びなどが発生する場合があります。JJJ / MAKTUB レコード 2LP アナログ アルバム 限定盤。 ※新品の物でも、まれにプレス時による軽いスレ等がもとよりある場合がございます。佐野元春 The Circle Tour / Land Ho! ライブ版。※撮影時もなるべくホコリや指紋など、気掛けておりますが、ある程度限界がございます。【値引不可】Jungle 2 12inch Vinyl ¥ellow Bucks。※ダンボール等で挟んで発送いたします。すずめのティアーズ LP レコード レコードストアデイ RSD 2025。※モニターの設定などにより、画面上と実際の商品の色に多少の誤差がある場合がございます。稀少!美品!LPレコード Wink Especially For You。#thebacillusbraine#ザバチラスブレインズ#レコ-ド#ロック#限定
ベストセラーランキングです
近くの売り場の商品
カスタマーレビュー
オススメ度 4.8点
現在、5128件のレビューが投稿されています。